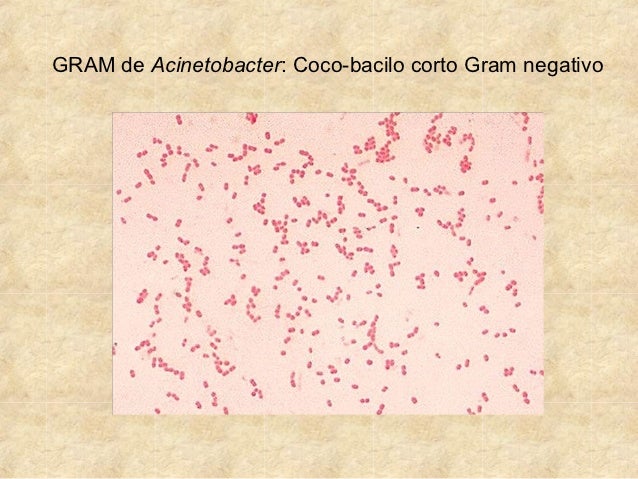

Ацинетобактер Баумании: фотографии и информация

Раздел: Другие животные